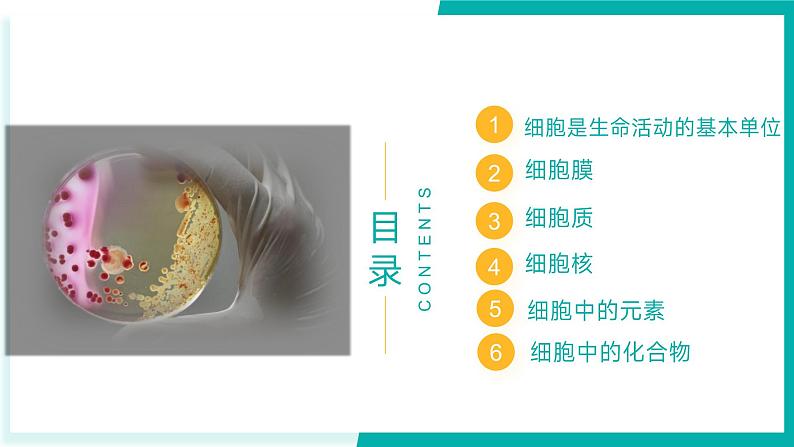

所属成套资源:高二生物下学期期末考点大串讲(人教版2019)
专题三 细胞的结构与功能(期末考点串讲)-2023-2024学年高二生物下学期期末考点大串讲(人教版2019)课件PPT
展开
这是一份专题三 细胞的结构与功能(期末考点串讲)-2023-2024学年高二生物下学期期末考点大串讲(人教版2019)课件PPT,共60页。PPT课件主要包含了细胞中的化合物,细胞中的元素,细胞膜,细胞质,细胞核,思维导图,考点01,考点梳理,细胞学说,生命系统的层次等内容,欢迎下载使用。
细胞是生命活动的基本单位
考点01 细胞是生命活动的基本单位
维萨里:揭示了人体在器官水平的结构
比夏:指出器官是由组织构成的
胡克:细胞的发现者和命名者
列文虎克:用显微镜观察到细菌等活细胞
马尔比基:用显微镜观察了动植物的微细结构
施莱登:提出细胞是构成植物体的基本单位
施旺:提出动植物细胞结构的一致性
耐格里:发现新细胞的产生是分裂的结果
魏尔肖:断言所有细胞都来源于先前存在的细胞
第三阶段科学观察和归纳概括的结合—形成理论
第四阶段细胞学说在修正中前进
第一阶段从人体的解剖和观察入手——从器官到组织
第二阶段显微观察资料的积累——认识细胞
①细胞是一个有机体,一切动植物都由细胞发育而来,并由细胞和细胞产物所构成。②细胞是一个相对独立的单位,既有它自己的生命,又对与其他细胞共同组成的整体的生命起作用。③新细胞是由老细胞分裂产生的。
①细胞学说揭示了动物和植物的统一性,从而阐明了生物界的统一性。②使人们认识到植物和动物有着共同的结构基础——细胞。③细胞学说的建立标志着生物学的研究进入到细胞水平,极大地促进了生物学的研究进程,并为后来的进入分子水平打下基础。④细胞学说中细胞分裂产生新细胞的结论,不仅阐释了个体发育,也为后来生物进化论的确立埋下了伏笔。
细胞是最基本的生命系统。
由形态相似,结构功能相同的细胞联合在一起构成的细胞群。
不同的组织按照一定的次序结合在一起构成的能行驶某些特定功能的结构。
能共同完成一种或几种生理功能的多个器官按照一定的次序结合在一起形成的结构。注意:植物没有系统
由各种器官或系统协调配合共同完成复杂的生命活动的单个生物。
在一定区域内,同种生物的所有个体组成一个种群。举例:某区域内所有的大熊猫或冷箭竹。
在一定区域内,所有的种群组成一个群落。举例:某区域内冷箭竹、大熊猫和其他所有生物。
生物群落与它的无机环境相互作用而形成的统一整体。最大的生态系统是生物圈。
转动转换器,换上高倍镜
调节光圈,使视野明亮适宜,调节细准焦螺旋直到物像清晰
四、比较原核细胞和真核细胞
无以核膜为界限的细胞核(拟核)
无核膜、核仁、无染色体,有环状DNA分子
多数有细胞壁,主要成分肽聚糖
有以核膜为界限的真正细胞核
有核膜、核仁、染色体(DNA+蛋白质 )
较大(10-100um)
植物细胞壁——纤维素和果胶;真菌细胞壁——几丁质;动物细胞无细胞壁
①都具有细胞膜和细胞质(都具有细胞器核糖体)②都以DNA为遗传物质
【典例01】生命系统存在着从细胞到生物圈各个不同的结构层次。下列相关叙述错误的是( )
A.草履虫可以看作是基本的生命系统,单细胞生物既是细胞层次又是个体层次B.生态系统中存在非生命的物质和成分,不属于生命系统C.病毒属于生物,但不属于任何生命系统结构层次D.植物体和动物体共有的生命系统层次有细胞、组织、器官、个体
解析:A、草履虫是单细胞生物,细胞是基本的生命系统,因此草履虫可以看作是基本的生命系统,单细胞生物既是细胞层次又是个体层次,A正确;B、生态系统的定义是在一定的地域内,生物与环境所形成的统一整体,不仅包含了生命系统,也包含了非生命的物质和成分,生态系统中的非生物成分是生命系统的一部分,它们与生物成分相互作用,共同维持生态系统的平衡和功能,B错误;C、病毒属于生物,但是属于无细胞结构生物,最基本的生命系统是细胞,因此病毒不属于任何生命系统结构层次,C正确;D、生命系统的结构层次从小到大进行划分,可以依次分为细胞、组织、器官、系统、个体、种群和群落、生态系统和生物圈,植物没有系统,因此动物与植物共有的生命系统层次有细胞、组织、器官、个体,D正确。
【典例02】支原体肺炎是由肺炎支原体引起的急性肺部感染性疾病。已知阿奇霉素可抑制原核生物核糖体中蛋白质的合成;青霉素可通过干扰细菌细胞壁的合成来使细菌裂解,从而达到杀菌的目的。下列说法错误的是( )
A.肺炎支原体的DNA上可能有蛋白质与之相结合B.支原体自身的蛋白质均在宿主细胞核糖体上合成C.阿奇霉素治疗支原体肺炎的效果比青霉素的显著D.人患病毒性流感时,不宜服用阿奇霉素进行治疗
解析:A、肺炎支原体的DNA上可结合DNA聚合酶或RNA聚合酶进行复制或转录,因此肺炎支原体的DNA上可能有蛋白质与之相结合,A正确;B、支原体为原核生物,具有核糖体,支原体可在自身细胞内的核糖体中合成蛋白质,B错误;C、肺炎支原体没有细胞壁,具有核糖体,阿奇霉素可抑制原核生物核糖体中蛋白质的合成;青霉素可通过干扰细菌细胞壁的合成来使细菌裂解,从而达到杀菌的目的,因此阿奇霉素治疗支原体肺炎的效果比青霉素的显著,C正确;D、病毒没有细胞结构,无核糖体,人患病毒性流感时,不宜服用阿奇霉素进行治疗,D正确。
【演练01】牛肝菌是常见的野生真菌,进食未加工成熟的牛肝菌会引起呕吐、腹痛及腹泻等中毒症状。环状八肽α-鹅膏蕈碱是毒蘑菇中常见的毒性物质。下列说法正确的是( )
A.牛肝菌细胞与乳酸菌细胞结构相似,遗传物质主要存在于环状DNA中B.α-鹅膏蕈碱由8个氨基酸脱水缩合而成,共脱去7分子水,含有7个肽键C.组成α-鹅膏蕈碱的元素一定有C、H、O、N,N元素主要存在于R基团中D.食用牛肝菌造成患者出现腹泻症状,患者不仅要补充水分还需要补充无机盐
【演练02】下列有关生命系统的叙述,不正确的是( )
A.细胞和生物圈分别是地球上最基本的生命系统和最大的生命系统B.肌肉细胞里的蛋白质和核酸属于生命系统的分子层次C.一个乳酸菌既属于细胞的层次也属于个体的层次,且不止含有一种核酸D.池塘中的水、空气没有生命现象,但它们也参与构成生命系统
1.将细胞与外界分隔开:
细胞膜将生命物质与外界环境分隔开,使细胞成为相对独立的系统,保障了细胞内部环境的相对稳定。
2.控制物质进出细胞:
细胞膜的功能特性:选择透过性
3.进行细胞间的信息交流:
(1)化学物质传递信息
(2)细胞膜直接接触传递信息
(3)胞间连丝传递信息
(内分泌)细胞分泌的信号分子(如激素),随体液到达全身各处,与靶细胞的(细胞膜表面或细胞内)受体结合,将信息传递给靶细胞。
相邻两个细胞的细胞膜接触,信息从一个细胞传递给另一个细胞。例如,精子和卵细胞的识别。细胞发出的信号分子与靶细胞细胞膜外表面的受体结合。
相邻两个细胞间形成通道,携带信息的物质通过通道进入另一个细胞。例如,高等植物通过胞间连丝进行信息交流。
1.欧文顿(E.Overtn)实验:
细胞膜是由脂质组成的。
2.对细胞膜进行成分分析:
细胞膜化学分析表明:脂质有磷脂和胆固醇,磷脂含量最多
亲水的“头部”与水接触,疏水的“尾巴”远离水
4.荷兰科学家戈特和格伦德尔:
细胞膜中的磷脂分子必然排列成连续的两层。
5.英国学者丹尼利和戴维森:
细胞膜除含脂质分子外,可能还附有蛋白质
1.20世纪40年代:
有学者推测脂质两边各覆盖着蛋白质。
2.1959年:罗伯特森实验
→电镜下细胞膜呈暗-亮-暗三层结构
↓提出假说:生物膜是由蛋白质-脂质-蛋白质三层结构构成,他把细胞膜描述为静态的统一结构。
人们对这一模型的异议增加了,不少科学家对于生物膜是静态的观点提出质疑。
膜静态模型不能解释下列现象:细胞的生长、分裂、变形虫的变形运动等现象都是难以实现的。把生物膜描述为静态的结构,这显然与膜功能的多样性相矛盾。
3.20世纪60年代:
实验方法:荧光标记法
4.人—鼠细胞融合实验:
1970年,弗雷和埃迪登( Frye 和 Edidin )等科学家用发绿色荧光的染料标记小鼠细胞表面的蛋白质分子,用发红色荧光的染料标记人细胞表面的蛋白质分子,将小鼠细胞和人细胞融合。
这一实验以及相关的其他实验证据表明,细胞膜具有流动性。
物理科学家将标本用干冰等冷冻,在低温下用冷刀将细胞膜切开,升温后暴露两层磷脂之间的断裂面(冷冻蚀刻法),发现蛋白质在膜中的分布情况。
蛋白质镶嵌、嵌入或贯穿于磷脂双分子层中。体现了膜结构内外的不对称性,不同上述蛋白质排列结构。
1972年桑格()和尼克森(G.Niclsn)提出了新的生物膜模型——流动镶嵌模型,为多数人所接受。
细胞膜的结构特点:具有一定的流动性细胞膜的功能特点:具有选择透过性
①有的镶嵌在磷脂双分子层表面(镶嵌) ②有的部分或全部嵌入磷脂双分子层中(嵌入) ③有的贯穿于整个磷脂双分子层(贯穿)
-----膜的基本支架
糖被(分布在细胞膜外侧,承担细胞识别、细胞间信息交流的作用)
细胞膜不是静止不动的,而是具有流动性,主要表现为构成膜的磷脂分子可以侧向自由移动,膜中的蛋白质大多也能运动。
【典例01】如今的生产工艺导致新鲜的蔬果表面常有水溶性的有机农药残留。现取新鲜红苋菜若干浸入一定量纯水中,每隔一段时间,取出一小片菜叶,测定其细胞液浓度,结果可绘制成下图的曲线(测得整个过程纯水的浓度变化较小)。下列叙述正确的是( )
A.AB段细胞吸水,显微镜下可见细胞体积明显增大B.B点时,细胞液与外界溶液没有水的交换C.AB段发生质壁分离,BC段发生质壁分离复原D.对红苋菜加热,随水温升高,水颜色变成红色的原因是加热使叶肉细胞的生物膜被破坏
解析:A、AB段细胞液浓度下降,说明细胞吸水,但由于细胞壁的存在,因此细胞体积不会明显增大,A错误;B、B点细胞液浓度最小,此时细胞液与外界溶液水的交换处于动态平衡,B错误;C、AB段细胞液浓度下降,说明细胞吸水,不会发生质壁分离,BC段细胞液浓度不断升高,说明BC段细胞开始失水,而质壁分离复原时细胞吸水,C错误;D、对红苋菜加热,随水温升高,水颜色变成红色的原因是加热使叶肉细胞的生物膜被破坏,导致细胞中色素释放出来,D正确。
【典例02】下列关于细胞生命大厦基本框架的描述,错误的是( )
A.磷脂双分子层构成所有生物膜的基本支架B.所有的生物大分子都以碳链作为基本骨架C.细胞骨架的蛋白质纤维由蛋白质和纤维素组成D.脱氧核糖和磷酸交替连接构成 DNA 的基本骨架
解析:A、磷脂双分子层是生物膜(包括细胞膜、核膜和细胞器膜)的基本支架,A正确;B、多糖、蛋白质、核酸等都是生物大分子,都是由许多单体连接而成的,每个单体都是以若干相连的碳原子构成的碳链为基本骨架,故生物大分子都是以碳链为骨架,B正确;C、真核细胞中的细胞骨架是由蛋白质组成的网架结构,C错误;D、脱氧核糖和磷酸交替连接构成 DNA 的基本骨架,D正确。
【演练01】细胞作为基本的生命系统,其结构复杂而精巧。下列有关叙述正确的是( )
A.细胞壁能将细胞与外界环境分隔开B.不同细胞膜上的蛋白质的种类与数量相同C.生物膜系统包括细胞膜、核膜以及细胞器膜等结构D.细胞骨架是由纤维素组成的网架结构
【演练02】神经细胞突触小泡中的乙酰胆碱浓度高于细胞溶胶的乙酰胆碱浓度,其转运机制如图所示。若将突触小泡离体培养在与神经元细胞溶胶成分相似的培养液中,下列叙述正确的是( )
A.生物膜中的蛋白质都与选择透过性有关B.细胞膜具有选择透过性只与膜上的转运蛋白有关C.适当增加培养液pH,可提高突触小泡对乙酰胆碱的摄取效率D.加药物增加膜对H+通透性,可提高突触小泡对乙酰胆碱的摄取效率
逐渐提高离心速度分离不同细胞器
外膜、内膜(向内腔折叠形成嵴[酶附着])、线粒体基质(含DNA、RNA、核糖体、呼吸氧化酶)
外膜、内膜、基质(含DNA、RNA、核糖体、光合作用合成酶)、基粒(类囊体堆叠形成,含酶、光合色素)
有氧呼吸主要场所细胞的动力车间
光合作用场所,植物细胞养料制造车间、能量转换站
内含细胞液(糖类/无机盐/色素[主要是花青素]脂质/氨基酸/核苷酸/酶等)
调节细胞渗透压(渗透吸水),充盈液泡使植物细胞保持坚挺
蛋白质等大分子物质的合成、加工场所和运输通道,脂质合成的车间;内连核膜,外连细胞膜;粗面内质网(加工修饰蛋白质)/光面内质网(脂质合成等)
对来自内质网的蛋白质进行加工、分类和包装的车间及发送站 ;细胞分泌物(动物细胞)、细胞壁形成(植物细胞合成多糖)
细胞的消化车间,内含多种水解酶(pH=5),分解衰老损伤细胞器、吞噬杀死侵入的病毒和细菌
rRNA和核糖体蛋白质构成亚基;附着于粗面内质网上或游离在细胞质基质中(可相互转化)
蛋白质的合成场所(合成多肽)生产蛋白质的机器
两个空间垂直的中心粒及周围物质构成,参与细胞有丝分裂
2层(外膜、内膜),还有类囊体薄膜
呼吸酶、DNA、RNA、核糖体
光合酶、光合色素、DNA、RNA、核糖体
维持细胞形态锚定并支撑着许多细胞器与细胞运动、分裂、分化以及物质运输、能量转化、信息传递等生命活动相关
由蛋白质纤维三组成的网架结构
在细胞内合成后,分泌到细胞外起作用的蛋白质。
消化酶、抗体和一部分激素
在游离核糖体上短肽,然后游离核糖体和短肽一起转移到内质网和高尔基体上加工,最后分泌到细胞外起作用。
在游离核糖体上合成,直接释放到细胞质基质中,不经过内质网-高尔基体分泌途径的修饰,只能用于构成该细胞自身结构。
3.分泌蛋白研究的科学方法:
4.分泌蛋白的合成步骤:
进一步修饰加工成成熟的蛋白质
(1)与分泌蛋白合成和运输有关的细胞器:
核糖体、内质网、高尔基体、线粒体
(2)参与分泌蛋白合成运输结构:
核糖体、内质网、高尔基体、线粒体、细胞膜
细胞器膜和细胞膜、核膜等结构,共同构成细胞的生物膜系统。
1.生物膜系统的概念
2.生物膜与生物膜系统的关系
★生物膜系统 ≠ 生物膜
①生物膜系统是指细胞内所有膜结构,而不是生物体内。
②只有真核细胞才有生物膜系统,原核细胞有生物膜,不具备生物膜系统。
3.生物膜在结构上的联系
①由磷脂双分子层构成基本骨架,蛋白质分子分布其中,都具有一定的流动性。
②在结构上具有一定的连续性
4.生物膜在功能上的联系
广阔的膜面积为酶提供了大量的附着位点
使细胞内部区域化,保证生命活动高效、有序地进行
保障细胞内部环境的相对稳定
物质运输、能量转换、信息传递
【典例01】图甲表示分泌蛋白的形成过程,其中a、b、c分别代表不同的细胞器,图乙表示该过程中部分结构的膜面积变化。下列相关叙述正确的是( )
A.图甲中的a、b、c共同参与构成生物膜系统B.图乙中三种膜结构都只通过囊泡建立联系C.神经细胞合成并分泌神经递质也需要经过图甲所示过程D.图甲中的分泌蛋白可能需要体液运输才能到达作用部位
解析:A、由图甲分析可知,a是核糖体,b是内质网,c是高尔基体,核糖体不参与构成生物膜系统,A错误;B、图乙中三种膜结构从左向右分别为内质网、高尔基体和细胞膜,内质网和细胞膜可以直接相连,也可以通过囊泡建立联系,B错误;C、神经递质大多为小分子物质,其化学本质不是蛋白质,不一定会经过图甲所示的过程,C错误;D、有些蛋白质类激素的合成和分泌要经过图甲所示过程,并通过体液运输到达作用部位,D正确。
【典例02】内共生起源学说认为,部分早期真核细胞吞噬光合细菌而演化成叶绿体,如图所示。据此推测不合理的是( )
A.叶绿体中有核糖体,能合成部分蛋白质B.光合细菌的双层细胞膜演化为了叶绿体的外膜和内膜C.叶绿体与光合细菌的基因组有明显相似性为该学说提供了证据D.早期真核细胞的溶酶体功能可能并不完善
解析:A、叶绿体起源于光合细菌,作为原核生物体内应该也会含有DNA、RNA和核糖体,能合成部分蛋白质,A正确;B、光合细菌的细胞膜是单层膜,识图可知叶绿体的外膜更可能来自于早期真核细胞的膜演化而来,内膜是光合细菌的细胞膜,B错误;C、内共生起源学说认为,部分早期真核细胞吞噬光合细菌而演化成叶绿体,叶绿体与光合细菌二者的基因组有明显相似性为该学说提供了证据,C正确;D、早期真核细胞吞噬光合细菌后并未完全消灭,因此推测其溶酶体功能可能并不完善,D正确。
【典例03】图是关于溶酶体发生过程和“消化”功能示意图,a~g表示结构,其中b表示刚形成的溶酶体,e表示包裹着衰老细胞器的小泡,下列相关叙述错误的是( )
A.溶酶体中的水解酶在高尔基体中合成B.溶酶体在执行“消化”功能时伴随膜组分的更新C.图示“消化”过程属于细胞自噬D.溶酶体还可清除感染细胞的微生物等
解析:A、水解酶的化学本质都是蛋白质,蛋白质的合成场所为核糖体,故溶酶体内的酶是由核糖体合成的,A错误;B、溶酶体在执行“消化”功能时需要与e具膜的结构融合,伴随膜组分的更新,B正确;C、图示过程为分解衰老、损伤的线粒体,属于细胞自噬,C正确;D、溶酶体含有多种水解酶, 还可清除感染细胞的微生物等,D正确。
【典例04】过氧化物酶体是一种内含过氧化氢酶等氧化酶类的单层膜细胞器,发生过程为:内质网出芽形成前体膜泡,然后过氧化物酶体的膜蛋白掺入;具有特定分选信号的基质蛋白借助信号序列与膜受体结合后进入形成成熟的过氧化物酶体。下列叙述错误的是( )
A.过氧化物酶体与溶酶体均能水解有机物B.膜蛋白的掺入为基质蛋白输入提供基础C.分选信号与基质蛋白在过氧化物酶体中行使功能无关D.过氧化物酶体膜上的脂质和蛋白质分别在内质网、核糖体上合成
解析:A、过氧化物酶体中主要含氧化酶类,可使有机物氧化分解,溶酶体中含有多种水解酶,使有机物水解,A错误;B、基质蛋白借助特定信号序列与膜受体结合而输入过氧化物酶体中,膜受体为膜蛋白,故膜蛋白的掺入为基质蛋白输入提供基础,B正确;C、分析题意,分选信号的作用是引导基质蛋白进入过氧化物酶体,进入后会被切除,故分选信号与基质蛋白在过氧化物酶体中行使功能无关,C正确;D、内质网是脂质的合成车间,核糖体是蛋白质的合成车间,过氧化物酶体膜上的脂质和蛋白质分别在内质网、核糖体上合成,D正确。
【演练01】溶酶体内pH明显低于细胞质基质,内含多种酸性水解酶。溶酶体的消化作用可概括成三种途径,如图所示。下列说法正确的是( )
A.内吞作用会导致细胞膜上的受体蛋白数量持续减少B.细胞质基质中的H+通过协助扩散的方式运至溶酶体内C.细胞饥饿时自噬作用会吞噬线粒体,不利于细胞代谢的稳定D.次级溶酶体破裂释放出水解酶,可能会导致细胞损伤进而引起细胞凋亡
【演练02】图中a、c表示某细胞中的两种结构,b是它们共有的结构(或特征)。下列有关叙述正确的是( )
A.若a、c分别代表蓝细菌的核糖体和细胞膜,则b可代表磷脂双分子层B.若a、c分别代表叶肉细胞的叶绿体和线粒体,则b可代表双层膜结构C.若a、c分别代表肌肉细胞的线粒体和细胞核,则b可代表染色体D.若a、c分别代表肺炎链球菌的核糖体和拟核,则b可代表脱氧核糖核酸
美西螈的肤色是由细胞核控制的
细胞核控制着细胞的分裂、分化
细胞核控制细胞的生命活动
生物体的形态结构主要与细胞核有关
细胞核是细胞的遗传和代谢的控制中心。
高等植物成熟的筛管细胞
1、___层膜(把细胞质与核内物质分开)2、核膜______连续的,上有小孔——_____3、核膜外膜与内质网膜_____相连4、核膜外膜上附着有________5、___________________通过核膜进出细胞核
1、实现_________频繁的物质交换和信息交流2、_________________进出的通道(RNA、蛋白质可进出,DNA不可以)3、细胞代谢强度越旺盛,核孔的数量______
1、与_______(rRNA)与_______的形成有关2、在细胞分裂的过程中____________________3、核仁的发达程度与蛋白质合成的_________有关
1、组成:主要是DNA和蛋白质2、容易被碱性染料染成深色的物质
染色质和染色体是同种物质在细胞不同时期的两种存在状态。
易被______染料染成深色
①染色质与染色体的关系:
高倍镜只能看到染色体,看不到染色质
有利于遗传物质的平均分配,从而将DNA中遗传信息从亲代传递给子代
有利于DNA中遗传信息的执行与复制
【典例01】如图表示细胞核的结构,下列关于细胞核的结构说法错误的是( )
A.③能够将核内物质与细胞质分开B.⑤与rRNA 的合成及核糖体的形成有关C.蛋白质合成旺盛的细胞中,⑥数量较多,④数目较多D.RNA 主要是通过⑥从细胞核到达细胞质的
解析:A、③是核膜,能够将核内物质与细胞质分开,A正确;B、⑤是核仁,与某种RNA(rRNA)的合成以及核糖体的形成有关,B正确;C、蛋白质合成旺盛的细胞中,⑥核孔数量较多,但④染色质数目不变,C错误;D、④核孔使细胞的核质之间能进行物质交换,是大分子的通道,如RNA可通过核孔进入细胞质,D正确。
【典例02】核孔是核质间进行物质交换和信息交流的通道,亲核蛋白须通过核孔进入细胞核发挥功能。非洲爪蟾卵母细胞亲核蛋白注射实验过程如图所示。下列相关叙述错误的是( )
A.核孔具有选择透过性,代谢旺盛的细胞的核孔数量多B.核膜为双层膜结构,其主要组成成分为蛋白质和脂质C.放射性的亲核蛋白及RNA不能通过核孔进入细胞核D.亲核蛋白是否能进入细胞核由尾部决定,仅有头部不能进入
解析:A、核孔是核、质之间频繁进行物质交换和信息交流的通道,核孔具有选择透过性,代谢旺盛的细胞的核孔数量多,A正确;B、核膜为双层膜结构,属于生物膜,其主要组成成分为蛋白质和脂质(主要是磷脂),B正确;C、据图可知,放射性标记的亲核蛋白能通过核孔从细胞质进入细胞核,C错误;D、分析题图,放射性尾部能从细胞质通过核孔进入细胞核中,但放射性头部却不能从细胞质通过核孔进入细胞核中,说明亲核蛋白进入细胞核由尾部决定,仅有头部不能进入,D正确。
【演练01】下列实验材料不能达到实验目的的是( )
A.伞藻嫁接和核移植实验探究细胞核功能B.利用新鲜菠菜观察植物质壁分离与复原C.通过豌豆杂交实验研究伴性遗传规律D.利用新鲜洋葱进行DNA的粗提取和鉴定
【演练02】核孔复合体控制物质通过核孔进出细胞核。下列叙述正确的是( )
A.人成熟红细胞核孔复合体的数量较少,因此红细胞代谢较弱B.参与组成染色质的蛋白质合成后通过核孔复合体进入细胞核C.物质通过核孔复合体在细胞核和细胞质之间的运输是单向的D.核孔、核仁、核膜和染色质等参与构成的细胞核是细胞代谢的中心
考点05 细胞中的元素
基本元素(占90%)鲜重最多
大量元素(占生物体的万分之一以上)
微量元素(生活必需,含量很少)
最基本元素(干重最多)
Fe Mn Zn Cu B M
分为大量元素和微量元素
她 请 杨 丹 留 人 盖 美 家C H O N S P Ca Mg K
铁 猛 碰 新 木 桶Fe Mn B Zn M Cu
花而不实(只开花不结果)
食欲减退、免疫力下降、影响生长发育等
影响植物叶绿素的合成,影响光合作用
成年人缺钙患骨质疏松症;人血液中缺钙会出现抽搐现象
【典例01】组成细胞的化学元素在无机自然界中都有存在,没有一种化学元素为细胞所特有。下列相关叙述错误的是( )
A.组成细胞的化学元素中,C、H、O、N的含量很高B.细胞中各种化学元素的相对含量与无机自然界相同C.组成细胞的化学元素大多以化合物的形式存在D.碳原子构成的碳链是生物大分子的基本骨架
解析:A、组成细胞的化学元素中,无论是鲜重还是干重,C、H、O、N四种元素在细胞中的含量都是最多的,A正确;B、细胞中各种化学元素的相对含量与无机自然界差异较大,B错误;C、组成细胞的元素大多以化合物的形式存在,包括有机物和无机物,D正确;D、碳原子构成的碳链是生物大分子的基本骨架,D正确。
【演练01】下列关于生物体内元素的叙述,正确的是( )
A.细胞中的脂质都是由C、H、O三种元素构成B.生物细胞内微量元素有Fe、Mn,Cu、Z,Ca、M等C.微量元素在生物体内含量很少,但其作用不可替代D.同一生物的各种细胞中元素种类都是相同的
【演练02】茶叶生产在中国已有3000多年的历史,其中信阳毛尖以“细、圆、光、直、多白毫、香高、味浓、汤色绿”的独特风格,盛名传播国内外。下列说法正确的是( )
A.Mg是微量元素,参与叶绿素组成B.茶叶和人体所含元素种类大致相同,但含量有差异C.采摘的新鲜茶叶的细胞中含量最高的化合物是蛋白质D.制好的成品茶相比新鲜茶叶结合水/自由水的比值低
考点06 细胞中的化合物
组成细胞的各种元素大多以化合物的形式存在
1.元素的存在形式:
2.化合物的种类和含量:
(1)细胞内含量最多的化合物 。(2)细胞内含量最多的无机化合物 。(3)占细胞鲜重含量最多的化合物 。(4)细胞内仅次于水的化合物 。(5)细胞内含量最多的有机化合物 。(6)占细胞干重含量最多的化合物 。(7)三种有机化合物含量在细胞中的比例: 。
二、生物组织中三大有机物检测
葡萄糖、果糖、半乳糖、乳糖、麦芽糖
等体积混合使用,现配现用。
还原糖将新制Cu(OH)2还原,生成砖红色的Cu2O
属于还原糖的有:单糖(葡萄糖、果糖、半乳糖)、二糖(麦芽糖、乳糖)
属于非还原糖的有:蔗糖、多糖
斐林试剂是甲液NaOH和乙液CuSO4混合后才可使用,因为其反应原理是还原糖中的醛基被Cu(OH)2氧化,Cu(OH)2被还原成Cu2O
颜色变化:浅蓝色→棕色→砖红色
脂肪+苏丹Ⅲ染液→橘黄色
花生种子: 富含脂肪且没有其他颜色干扰。
苏丹Ⅲ(苏丹Ⅳ)染液2~3滴
染色3 min(或1 min)
50%_____溶液1~2滴
先在低倍镜下寻找已着色颗粒,再用高倍镜观察
在碱性条件下,肽键与双缩脲试剂中Cu2+作用,产生紫色络合物
A:0.1g/mL的NaOH溶液 B:0.01g/ mL的CuSO4溶液
稀释10倍以上,否则实验后易黏附在试管壁上
双缩脲试剂是使用时先加A液,再加B液,因为其反应原理是具有两个或以上肽键的化合物在碱性条件下与Cu2+反应生成紫色络合物,所以要先营造一个碱性环境。
0.1g/mLNaOH
0.05g/mLCuSO4
0.01g/mLCuSO4
还原糖(葡萄糖、麦芽糖等)
甲、乙液等量混合均匀后注入
先加入A液摇匀,后加入B液摇匀
50-650C水浴加热
蓝色→棕色→砖红色沉淀
还原性糖+Cu(OH)2→Cu2O (砖红色沉淀)
碱性条件下蛋白质(含两个以上肽键)+Cu2+→紫色络合物
(1)唯一需要加热—— 鉴定,且必须水浴加热, 不能用酒精灯直接加热。若不加热则无砖红色沉淀出现。
(2)非还原糖(如蔗糖)+斐林试剂的现象不是无色而是浅蓝色[Cu(OH)2的颜色]。
(3)唯一需要显微镜—— 鉴定,实验中要用 ,其作用是 。
(4)若用大豆作材料,必须提前浸泡;若用蛋清作材料,必须稀释,防止其粘在试管壁上不易刷洗; 且该实验应预留部分组织样液做对比。
(5)易写错别字提示:“斐林试剂”中的“斐”不可错写成“非”,双缩脲试剂中的“脲”不可错写成“尿”。
1.水在细胞中的含量:
水在构成生物体化合物中含量第一;不同种生物含水量不同;水生生物含水量>陆生生物。
同一生物不同生长发育时期,含水量不同;幼年>成年>老年;幼嫩>成熟
同种生物的不同组织、器官,含水量不同。
②参与细胞内许多的生物化学反应
③构成多细胞生物体内以水为基础的液体环境
④运送营养物质和代谢废物
2.水在细胞中的作用:
水是极性分子,带正电或负电的分子容易与之结合,故是良好溶剂。
(2)形成氢键,具有流动性
氢键易被破坏,也易形成,这样水中的氢键不断地断开,又不断地形成,使水在常温下能够维持液体的状态。
(3)具有较高的比热容
由于氢键的存在,水具有较高的比热容,这就意味着水的温度相对不容易改变,水的这种特性,对于维持生命系统的稳定性十分重要。
自由水:以游离形式存在,可以自由流动,占细胞内全部水的95%以上。
结合水:与细胞内其它物质蛋白质、多糖等物质)相结合,约占细胞内全部水的4.5%。
4. 水的存在形式:
细胞代谢减弱,抗逆性增强
阴离子:Cl-、SO42-、PO43-、HCO3-等
阳离子:Na+、Ca2+、Mg2+、Fe2+等
如:DNA中的磷酸,骨骼中的钙等
无机盐是细胞中含量很少的无机物,仅占细胞鲜重的1%-1.5%。
(1)构成细胞中某些复杂化合物的组成成分
(2)维持细胞和生物体的生命活动
(3)维持细胞的渗透压平衡(正常形态)
(4)维持细胞的酸碱平衡
Mg2+ ━━Ca2+ ━━Fe2+ ━━I- ━━N- ━━P- ━━Na+K+ ━━B- ━━
维持生命活动,牙齿和骨骼的重要成分
促进花粉萌发和花粉管伸长
探究无机盐X是否为植物生长发育所必需
若缺乏某无机盐,植物生长发育发生障碍。植物在缺乏该种无机盐环境中表现某一症状,可补充该种无机盐使植物恢复。
动物脂肪大多数是含有饱和脂肪酸,熔点高,在室温时呈固态。
植物脂肪大多数是含有不饱和脂肪酸,熔点低,在室温时呈液态。
脂肪和糖相比,脂肪中“C”“H”含量高,“O”含量低,脂肪氧化分解释放的能量多,需要O2多,产生的H2O多。
①脂肪不溶于水;糖类可以。②脂肪氧化分解速率慢;糖类则较快。③脂肪必须在有氧条件下分解;糖类在有氧或无氧条件下均可。④有些器官或组织(例如:大脑和神经组织)必须由糖类来供能。
(1)等量的脂肪比糖类含能量多原因
(2)脂肪不是主要能源物质的原因
C、H、O、N、(S、Fe)
组成蛋白质的氨基酸种类不同氨基酸的数目不同氨基酸排列顺序不同多肽的空间结构不同
构成生物体,如结构蛋白运输作用,如血红蛋白催化作用,如酶调节作用,如胰岛素免疫作用,如抗体
至少有一个-NH2和一个-COOH连在同一个C原子上
蛋白质在某些物理或化学因素作用下,其特定的空间构象被破坏,从而导致其理化性质改变和生物活性丧失的现象。
物理因素:加热、紫外线、X射线、超声波、剧烈振荡
化学因素:强酸、强碱、重金属盐等
①用酒精、加热、紫外线等来消毒和杀菌。
②在重金属盐中毒急救。
胃蛋白酶、胰蛋白酶、肠肽酶等
不同的蛋白酶作用的部位(肽键)有差异,蛋白酶分解蛋白质得到的产物是小分子多肽和氨基酸;肽酶会从肽链的一端逐个水解肽键,得到的产物是氨基酸。
蛋白质在盐溶液中溶解度降低析出溶解度的变化,可逆
【典例01】某生物兴趣小组以一种白色野果为实验材料,对白色野果组织样液进行了有机物的鉴定下列叙述正确的是( )
A.加入斐林试剂的本质是新制的Cu(OH)2,水浴加热,样液呈现砖红色,说明含有果糖B.双缩脲试剂在使用时需要等量混合,现用现配C.斐林试剂和双缩脲试剂中都有0.1g/mL的NaOH溶液D.鉴定组织样液中的脂肪需要制作临时装片在显微镜下观察,用苏丹Ⅲ染液染色后需要用75%酒精洗去浮色
解析:A、加入斐林试剂的本质是新制的Cu(OH)2,水浴加热,样液呈现砖红色,说明含有还原糖,但不一定是果糖,A错误;B、斐林试剂在使用时需要等量混合,现用现配,双缩脲试剂则是先向待鉴定材料加入A试剂(0.1g/mLNaOH溶液)摇匀后,再加入试剂B(0.01g/mLCuSO4溶液),B错误;C、斐林试剂和双缩脲试剂都由NaOH溶液和CuSO4溶液构成,它们中都有0.1g/mL的NaOH溶液,C正确;D、鉴定组织样液中的脂肪需要制作临时装片在显微镜下观察,用苏丹Ⅲ染液染色后需要用50%酒精洗去浮色,D错误。
【典例02】下列有关细胞中元素及化合物的叙述,错误的是( )
A.ATP、DNA和磷脂分子的组成元素相同B.Fe2+参与构成的血红蛋白的主要功能是运输血液中的O₂C.大多数糖类分子中H和O的数量之比类似于H2O,因而糖类又称为“碳水化合物”D.煮熟牛肉中的蛋白质,不能与双缩脲试剂发生反应
解析:A、ATP、DNA和NADPH的组成元素均为C、H、O、N、P,A正确;B、构成血红蛋白的血红素中含有Fe元素,血红蛋白的主要功能是运输血液中的O₂,B正确;C、多数糖类分子中氢原子和氧原子之比是2:1,类似水分子,因而糖类又称为“碳水化合物”,C正确;D、煮熟牛肉中的蛋白质含有肽键,能与双缩脲试剂发生反应,D错误。
【典例03】下面是关于脂质的叙述,其中正确的是( )
A.磷脂由C、H、O、N、P元素组成,是构成细胞各种膜结构的主要成分B.脂肪由一分子脂肪酸和三分子甘油组成,大多数动物脂肪含有饱和脂肪酸,具有储存能量和保护内脏等作用C.性激素可用双缩脲试剂检测,对动物的生长发育和生殖等起重要的调节作用D.胆固醇是细胞膜的必要组分,可以参与血液中脂质的运输
解析:A、磷脂中除C、H、O三种元素外,还含有N、P元素,是构成细胞各种膜结构的主要成分,A正确;B、脂肪是由三分子脂肪酸与一分子甘油发生反应而形成的酯,即三酰甘油,植物脂肪大多含有不饱和脂肪酸,大多数动物脂肪含有饱和脂肪酸,脂肪具有储存能量和保护内脏等作用,B错误;C、性激素的化学本质是固醇,属于脂质,不能用双缩脲试剂检测,C错误;D、胆固醇是动物细胞膜的重要组成成分,胆固醇不是细胞膜的必要组分,D错误。
【典例04】生物体内蛋白质的合成、加工是一个十分复杂的过程,其中多肽链的正确折叠对其正确构象的形成至关重要。如果蛋白质折叠发生错误,蛋白质的构象就会发生改变,影响其功能,严重时会引发疾病。有些蛋白质错误折叠后还会相互聚集,形成抗蛋白水解酶的淀粉样纤维沉淀,产生毒性而致病。此类疾病称为蛋白质构象病,下列相关说法正确的是( )
A.多肽链的形成以及折叠过程均发生在核糖体上B.蛋白质构象病均可遗传给后代,属于遗传病C.题述淀粉样纤维沉淀的主要成分是淀粉和蛋白质D.蛋白质构象是否发生改变不能用双缩脲试剂来判别
解析:A、多肽链的形成在核糖体,折叠过程发生在内质网,A错误;B、如果蛋白质构象病发生在体细胞中,就不会遗传给后代,B错误;C、根据题干信息淀粉样纤维沉淀是由于蛋白质折叠错误,形成的抗蛋白水解酶的物质,所以主要成分是蛋白质,不含淀粉,C错误;D、蛋白质构象发生改变,含仍然含有多个肽键,可与双缩脲试剂产生紫色反应,因此不能用双缩脲试剂来判别蛋白质构象是否发生改变,D正确。
【典例05】2022年4月,全国农作物品种DNA指纹库公共平台正式上线运行,实现了“农作物DNA指纹档案”的线上共用共享,解决了品种真实性鉴定中标准样品取样难、耗时长、侵权案件审判时效性差等问题,也为避免同质化育种提供了“参考数据库”。关于DNA指纹技术,下列相关说法错误的是( )
A.小麦细胞遗传信息蕴藏在脱氧核苷酸的排列顺序中B.小麦细胞遗传物质中有2种五碳糖,5种碱基,8种核苷酸C.DNA指纹技术的依据是不同品种农作物细胞中DNA所含的碱基序列不同D.每个人的DNA指纹是独一无二,也可以根据DNA指纹技术帮助确认身份
解析:A、小麦细胞的遗传物质是DNA,小麦细胞遗传信息蕴藏在脱氧核苷酸的排列顺序中,A正确;B、小麦细胞的遗传物质是DNA,有1种五碳糖,4种碱基,4种核苷酸,B错误;C、不同DNA所含碱基排列顺序不同,属于DNA分子的特异性,可以根据这一点来进行不同DNA分子的鉴定,C正确;D、DNA分子的特异性主要表现为每个DNA分子都有特定的碱基序列,这也是DNA指纹的主要依据,D正确。
【典例06】关于下列四图的叙述中,正确的是( )
A.甲图和丙图分别是构成生物体遗传信息的携带者和生命活动的主要承担者的基本单位B.乙图小麦种子在晒干和烘烤过程中所失去的水都主要是自由水C.若丙图中a为脱氧核糖,则由b构成的核酸完全水解,得到的化合物最多有6种D.在小鼠的体细胞内检测到的化合物丁很可能是蔗糖
解析:A、甲图为氨基酸,是生命活动的承担者(蛋白质)的基本单位;丙图为核苷酸,是构成生物体遗传信息的携带者(核酸)的基本单位,A错误;B、乙图晒干失去的主要是自由水,烘烤主要失去的是结合水,B错误;C、丙图中a为脱氧核糖,则由b构成的核酸为DNA,则完全水解可得到磷酸、脱氧核糖、4种含氮碱基共6种产物,C正确;D、丁图为二糖,动物细胞具有的二糖为乳糖,蔗糖是某些植物含有,D错误。
【典例07】豆制品是以大豆、豌豆等豆类为主要原料加工而成的食品。它营养丰富,除含人体必需氨基酸外,还含有磷脂、脂肪、纤维素等,几乎不含胆固醇。下列说法正确的是( )
A.以碳链为基本骨架的脂肪分子是大豆细胞内良好的储能物质B.磷脂是构成细胞膜及细胞器膜的重要成分,组成元素有C、H、O、N、SC.豆制品中含有的纤维素,在人体消化道被分解为葡萄糖后,才能被吸收利用D.脂肪、磷脂、胆固醇分子结构差异不大,都不溶于水,而溶于有机溶剂
解析:A、脂肪分子也是以碳链为基本骨架的分子,脂肪含氢多,含氧少,是细胞内良好的储能物质,A正确;B、磷脂双分子层构是生物膜的基本支架,所以磷脂是构成细胞膜和细胞器膜等的重要成分,磷脂的组成元素有C、H、O、N、P,B错误;C、人体内没有纤维素酶,则不能消化纤维素,C错误;D、脂肪、磷脂、胆固醇分子结构差异很大,都不溶于水,而溶于有机溶剂,D错误。
【演练01】化学元素在生物体的化学组成和功能上发挥着重要作用。下列有关生物体内化学元素的叙述,正确的是( )
A.核苷酸和NADPH组成元素均有C、H、O、N和PB.组成细胞的各种元素大多数以离子的形式存在C.哺乳动物血钙过高将导致肌肉发生抽搐现象D.植物缺乏微量元素Mg会影响其叶绿素的形成
【演练02】某生物兴趣小组进行了生物组织中还原糖检测的实验,如图所示。下列相关叙述正确的是( )
A.向组织样液中先加入斐林试剂乙液,以营造碱性环境B.也可以选用梨匀浆或葡萄匀浆代替苹果进行实验C.加入石英砂的目的是抑制苹果果肉褐变,以免影响实验结果D.试管内有砖红色沉淀生成,说明组织样液中含有淀粉等还原糖
【演练03】早稻秧田在寒潮来临前深灌,可起保温防寒作用;施肥后灌水,可起溶肥作用。下列叙述正确的是( )
A.电子的不对称分布使水具有较高的比热容,水温相对不容易发生改变,利于深灌保温B.水分子之间以氢键相连使水分子具有极性,有利于溶肥促进植物的吸收C.水在细胞代谢中既可以是反应底物,也可以是代谢产物D.随着气候变冷,植物细胞内自由水相对含量增加,抗寒能力增强
【演练04】如图表示糖类的化学组成和种类,下列有关糖类的叙述正确的是( )
A.①②③它们均可继续水解,其中①②还属于还原糖B.④⑤分别为纤维素、肌糖原,二者均储存能量,可作为储能物质C.图中均为提供能量的糖类D.几丁质又称壳多糖,多种生物含有,能与重金属离子有效结合,可用于废水处理
【演练05】线粒体中的部分蛋白质是由核基因编码。先在线粒体外合成前体蛋白,然后在信号序列的引导下,进入线粒体加工为成熟蛋白质。过程如图所示。下列推测错误的是( )
A.前体蛋白进入线粒体时,空间结构发生了改变B.前体蛋白在线粒体内加工成熟的过程需要酶的参与C.核基因控制的蛋白质有选择性地进入线粒体中,并不是直径小于转运通道直径就可进入线粒体D.前体蛋白信号序列与受体识别的过程体现了生物膜之间的信息交流
【演练06】下图为核苷酸的模式图,下列说法正确的是( )
A.组成②和③的元素相同B.②能作为生物体的能源物质C.组成DNA与RNA的核苷酸只有②不同D.若③表示胸腺嘧啶,则该图所示物质的名称一定是胸腺嘧啶脱氧核苷酸
【演练07】如图表示不同化学元素所组成的化合物,以下说法错误的是( )
A.若②普遍存在于人体皮下和内脏等部位,则②最可能是脂肪B.若④主要在人体肝脏和肌肉内合成,则④最可能是糖原C.若③为生物大分子,且能贮存生物的遗传信息,则③在人体内是DNAD.若图中①为某种生物大分子的基本组成单位,则①可能是各类氨基酸且组成元素均相同
【演练08】下列关于脂质的叙述,错误的是( )
A.等质量的油脂与葡萄糖相比,氧化分解时放出能量更多B.磷脂与油脂的元素组成相同,是各种生物膜的组成成分C.维生素D可促进人和动物对钙的吸收D.胆固醇是动物细胞膜的重要成分,但摄入过多有害健康
相关试卷
这是一份专题五 细胞的生命历程(期末考点串讲)-2023-2024学年高二生物下学期期末考点大串讲(人教版2019)课件PPT,共44页。PPT课件主要包含了细胞的死亡,细胞的衰老,细胞的增殖,细胞的有丝分裂,细胞的分化和全能性,考点01,考点01细胞的增殖,考点02,考点03,考点04等内容,欢迎下载使用。
这是一份专题四 细胞的代谢(期末考点串讲)-2023-2024学年高二生物下学期期末考点大串讲(人教版2019)课件PPT,共60页。PPT课件主要包含了光合作用,细胞的物质输入和输出,酶与ATP,细胞呼吸,思维导图,物质跨膜运输的实例,考点01,渗透作用,渗透系统变式分析,水进出细胞的原理等内容,欢迎下载使用。
这是一份专题二 细胞工程与胚胎工程(期末考点串讲)-2023-2024学年高二生物下学期期末考点大串讲(人教版2019)课件PPT,共60页。PPT课件主要包含了胚胎工程的应用,体内受精和胚胎发育,思维导图,植物细胞工程,考点01,考点02,考点03,考点04,考点05,考点06等内容,欢迎下载使用。